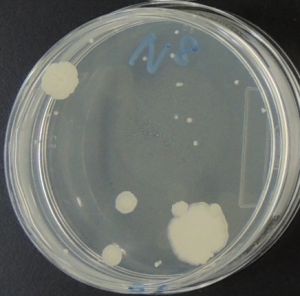
１億倍に薄めたコロニー
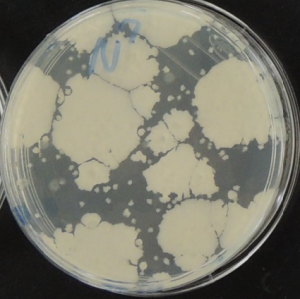
１千万倍に薄めたコロニー
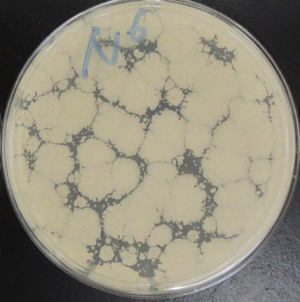
100万倍に薄めたコロニー

身近な菌を見てみよう!~納豆~
印刷用ページを表示する掲載日2024年7月26日
納豆の中の菌を見てみよう!
納豆は,煮た大豆を納豆菌で発酵させた日本の伝統的な発酵食品であり,昔から食べられてきました。今回は,納豆の中にどんな菌がいるのか見てみましょう。
まず,納豆をミキサーでドロドロの状態にしたものを生理食塩水で10倍ずつ薄め,培地(菌を発育させる栄養分が入った寒天)と混ぜて36℃で一晩置くと,(写真1~3)のように,白い塊(コロニー:1つの菌が目に見えるまで増えたもの)が出てきます。
薄めた倍率:1億倍(写真1)
薄めた倍率:1億倍(写真1)
薄めた倍率:1千万倍(写真2)
薄めた倍率:1千万倍(写真2)
薄めた倍率:100万倍(写真3)
薄めた倍率:100万倍(写真3)
出てきたコロニーを採って,青紫色の色素で染め,顕微鏡で1000倍に拡大して見ると,(写真4)のように,たくさんの菌が見えてきました。これが,納豆の中にいる菌です。
 (写真4)
(写真4)
検査した納豆にいた菌の数は,1g 中に23億個でした。つまり,この納豆1パック(30g入り)を食べたら,約690億個の菌を食べたことになります。
